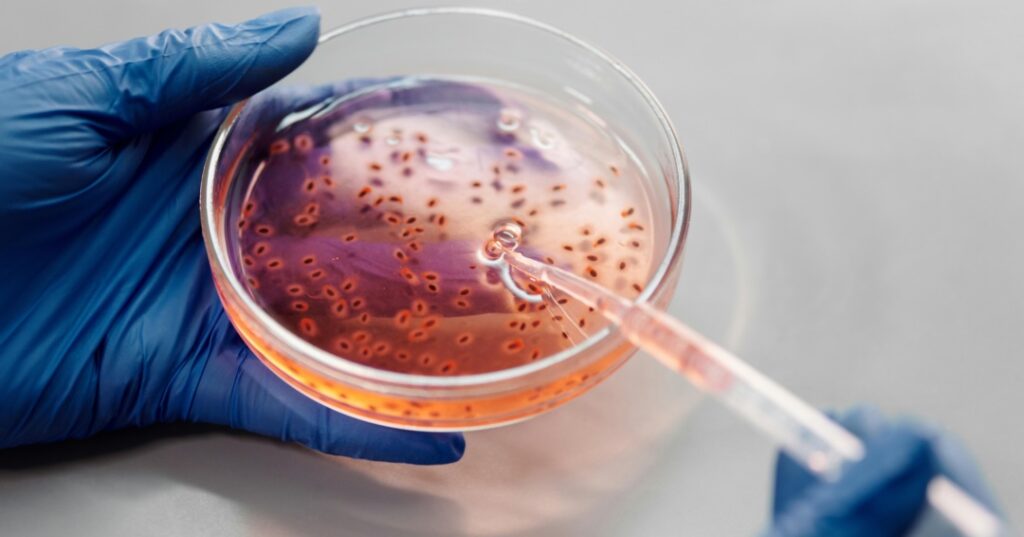
Bacterias modificadas genéticamente

Una solución clínica basada en la aplicación de bacterias modificadas genéticamente para activar el sistema inmunológico permitiría atacar tumores de forma específica y optimizar la efectividad de la inmunoterapia.
La búsqueda de nuevos métodos para combatir el cáncer parece haber dado con un acierto. Un enfoque novedoso que está ganando auge es el uso de bacterias como vacunas contra el cáncer. Son bacterias modificadas genéticamente, capaces de activar el sistema inmunológico para que ataque los tumores de forma específica. Investigaciones recientes con resultados alentadores brindan esperanzas a millones de personas que enfrentan esta enfermedad.
Nueva esperanza
La genética modificada de las bacterias las transforma en una suerte de «vacunas contra el cáncer» que, al ser inoculadas, en lugar de causar infecciones, funcionan como señales de advertencia para el cuerpo, estimulando las células inmunitarias para que ataquen los tumores. En el organismo, las bacterias se infiltran en los tumores y liberan compuestos que intensifican la respuesta del sistema inmune que responde dirigiendo sus ataques hacia las células cancerosas.

Un estudio publicado por Nature Communications mostró que Listeria monocytogenes, una bacteria modificada genéticamente, redujo tumores en ratones con cáncer. Otro estudio publicado en Science Translational Medicine demostró que bacterias como Salmonella y Clostridium también pueden ser utilizadas para destruir tumores desde el interior, mejorando los resultados de otros tratamientos como la quimioterapia y la inmunoterapia.
Ventajas
Utilizar bacterias como vacunas aprovecha la capacidad para dirigirse específicamente a las células tumorales, minimizando el daño a los tejidos sanos. Esto ayuda a reducir los efectos secundarios que suelen acompañar a terapias convencionales como la quimioterapia y la radioterapia. Además, las bacterias pueden acceder a áreas de los tumores que otros tratamientos no alcanzan, lo que las convierte en una herramienta valiosa, especialmente en el tratamiento de cánceres en fases avanzadas.

Otras formas de inmunoterapia podrían beneficiarse también mediante combinaciones que incrementen sus efectos. Un estudio de Frontiers in Oncology demostró que, al combinar bacterias con inhibidores de puntos de control inmunitario, los pacientes obtuvieron una mejor respuesta tumoral y mayor supervivencia.
Casos prometedores
Si bien la mayor parte de la investigación se ha realizado en animales, ya se están llevando a cabo ensayos clínicos en humanos. Según datos de ClinicalTrials.gov, varios estudios en fase 1 y 2 están evaluando la efectividad de estas bacterias en pacientes con cáncer de pulmón, melanoma y cáncer de colon. Los resultados preliminares han sido alentadores, con una reducción significativa de los tumores en algunos pacientes.

El MD Anderson Cancer Center llevó adelante un estudio en el que investigadores utilizan una bacteria modificada genéticamente para tratar el cáncer de páncreas. Los primeros resultados demostraron que la bacteria es bien tolerada por los pacientes y ha mostrado efectos positivos en la reducción de los tumores.
Desafíos y futuro del tratamiento
En tiempos recientes, un equipo científico de la Universidad de Columbia trabaja en la elaboración de una vacuna contra el cáncer a base de bacterias previamente modificadas, capaces de desencadenar la activación inmune y atacar células cancerosas. Esta solución también enfrenta desafíos. Garantizar que las bacterias no provoquen efectos negativos en los pacientes, como infecciones o inflamaciones graves, supone uno de los primeros desafíos.

A la fecha, trabajan en ajustar las dosis y mejorar la seguridad de los tratamientos para que sean viables en un futuro próximo. Dados los primeros hallazgos alentadores, se espera que en los años por venir más ensayos clínicos se desarrollen en busca de resultados definitivos sobre la seguridad y efectividad de las bacterias anticancerígenas.
Aunque aún queda mucho por investigar, la posibilidad de utilizar bacterias para estimular el sistema inmune y atacar tumores es una gran esperanza en la lucha contra el cáncer.

FUENTE: Wokii.
IMÁGENES: Pexels.



